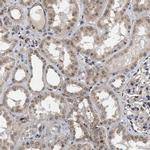
CLIP2 Antibody in Immunohistochemistry (IHC)

Search
Invitrogen
CLIP2 Polyclonal Antibody
{{$productOrderCtrl.translations['antibody.pdp.commerceCard.promotion.promotions']}}
{{$productOrderCtrl.translations['antibody.pdp.commerceCard.promotion.viewpromo']}}
{{$productOrderCtrl.translations['antibody.pdp.commerceCard.promotion.promocode']}}: {{promo.promoCode}} {{promo.promoTitle}} {{promo.promoDescription}}. {{$productOrderCtrl.translations['antibody.pdp.commerceCard.promotion.learnmore']}}
产品信息
PA5-54205
种属反应
宿主/亚型
分类
类型
抗原
偶联物
形式
浓度
规格
纯化类型
保存液
内含物
保存条件
运输条件
RRID
产品详细信息
Immunogen sequence: SSSISSVSSV ASSVGGRPSR SGLLTETSSR YARKISGTTA LQEALKEKQQ HIEQLLAERD LERAEVAKAT SHICEVEKEI ALLKAQHEQY VAEAEEKLQR ARLLVESVRK EKVDLSNQLE EERRKVEDLQ FRVEEESITK GDLELTTVA
Highest antigen sequence identity to the following orthologs: Mouse - 99%, Rat - 97%.
靶标信息
The protein encoded by this gene belongs to the family of cytoplasmic linker proteins, which have been proposed to mediate the interaction between specific membranous organelles and microtubules. This protein was found to associate with both microtubules and an organelle called the dendritic lamellar body. This gene is hemizygously deleted in Williams syndrome, a multisystem developmental disorder caused by the deletion of contiguous genes at 7q11.23. Alternative splicing of this gene generates 2 transcript variants.
仅用于科研。不用于诊断过程。未经明确授权不得转售。
篇参考文献 (0)
生物信息学
蛋白别名: CAP-Gly domain-containing linker protein 2; CLIP-115; cytoplasmic linker 2; Cytoplasmic linker protein 115; Cytoplasmic linker protein 2; KIAA0291; testicular tissue protein Li 40; Williams-Beuren syndrome chromosomal region 3 protein; Williams-Beuren syndrome chromosomal region 4 protein; Williams-Beuren syndrome chromosome region 3; Williams-Beuren syndrome chromosome region 4
基因别名: CLIP; CLIP-115; CLIP2; CYLN2; KIAA0291; WBSCR3; WBSCR4; WSCR3; WSCR4
UniProt ID: (Human) Q9UDT6
Entrez Gene ID: (Human) 7461